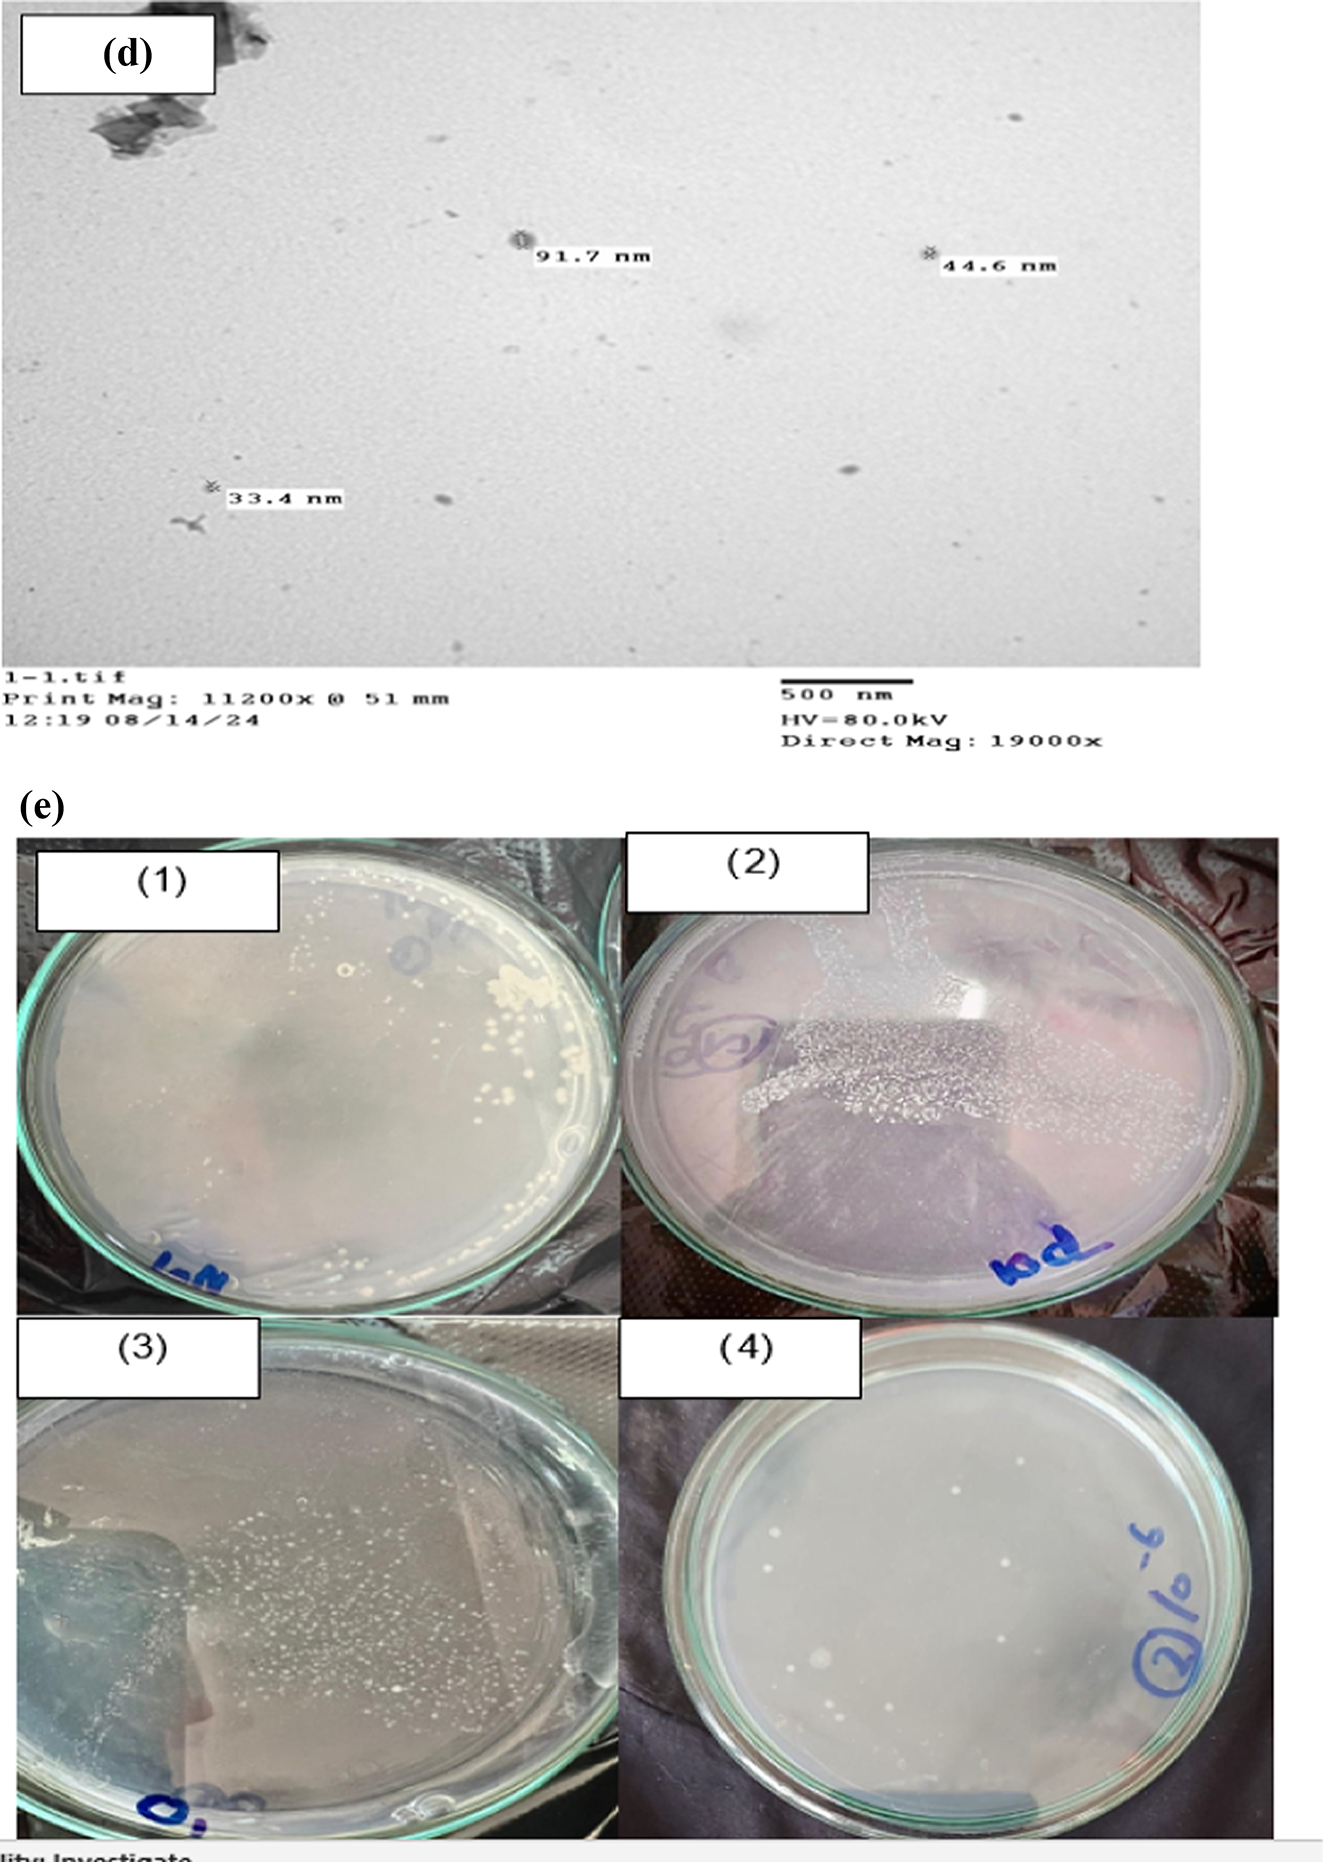
Fig. 4

Fig. 4

Calcium carbonate precipitation by Bacillus subtilis(g/L) after growth for 30 days in minimal medium supplemented with four levels of four calcium salts (citrate “Ci” acetate “Ac”, nitrate “N” and chloride “Cl”) (a); development of calcium carbonate precipitation over time of 30 days at successively increasing concentrations of CaCl2 (b); Scanning electron micrographs (SEM) showing shapes and morphogenesis of calcium carbonate precipitations produced by Bacillus subtilis at the provided calcium salts (c) [4cCi, 4cAc, 4cN and 4cCl for citrate, acetate, nitrate, and chloride, respectively]; (d) transmission electron micrographs (TEM) showing nanoparticles of calcium carbonate precipitations produced by Bacillus subtilis at the provided calcium chloride and viability of bacterial cells in calcium carbonate precipitates (e1-4) and.
